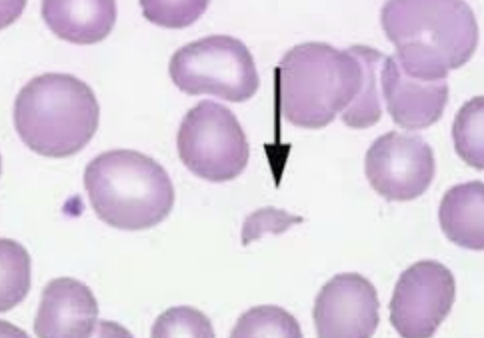

PART 2: Ultimate Tier USMLE Images Test Questions Prepare to be mindblown with High Yields. Read below⬇️ Let's make this one go viral too! (will tag Part 1 at end)
45yo with history of syncope, angina and dyspnea. Symptoms are now improved after intervention and you see this CXR. What was original diagnosis?
Bicuspid aortic valve! CXR shows an aortic valve replacement What else could this patient have? - Hemolytic anemia with schistocytes from shearing RBC across the valve What would EKG show? - LVH Dx: ECHO, if inconclusive --> heart Cath with pressure gradient > 30-40mmHg
Don't ask me why...but AVR criteria is showing up now on USMLE rarely: - Repair if patients are SYMPTOMATIC or EF < 50% *Bioprosthetic valves = do not require lifelong anticoagulation *Mechanical valves = must be anticoagulated (warfarin usually)
Pregnant woman presents with this rash. No other symptoms Tx?
Answer: Treat Lyme disease with amoxicillin/cefuroxime x3w (if pregnant or nursing) Btw, the USMLE knows that everyone knows Amoxicillin for Lyme if pregnant...so be on the lookout for CEFUROXIME as an answer choice!!
Concise Algorithm for Lyme management (MUST KNOW FOR NBME) Early localized w/ just rash: - 1st line: Doxy x2 weeks (avoid if pregnant) - 2nd line: amoxicillin/cefuroxime x3w (if pregnant or nursing)
Lyme Tx Part 2: Early disseminated (meningitis/Bell's palsy): - If just has Bell's palsy = Doxy - If Meningitis/Carditis = IV 3rd gen cephalosporin OR Penicillin G x4w Late Lyme (arthritis/encephalopathy) - Doxy or amoxicillin x 4w
40yo F with these rashes + deltoid 2/5 strength bilaterally. Dx?
Answer: Dermatomyositis (watch for gastric/ovarian carcinoma & interstitial lung disease!) Note: these Gottron's papule & heliotrope eye rash are assoc w/ CD4+. What other rash comes to mind in patient that's immunocompromised with CD4+ erythroderma? - Mycosis Fungoides!
HY Association: If someone presents after a car crash and they have similar raccoon eyes, what is your diagnosis? - Basilar skull fracture! *Can have high CHLORIDE clear fluid draining from nose = CSF from fractured cribriform plate! Look for: mastoid ecchymosis (Battle sign)
HY Myositis comparison: How do you differentiate between dermatomyositis and inclusion body myositis (IBM)? Both can have elevated CK/CRP, however: - IBM = basophilic rimmed vacuoles endomysial inflam (recall: polymyositis has endomysial inflam too) - Dermato= anti-Jo1/SRP/Mi-2
HY Tie-in: History of HIV, now with proximal muscle weakness. What med caused this? - Zidovudine myopathy! --> Biopsy can have ragged red fibers like mitochondrial disorders (MELAS / Leber Hereditary Optic Neuropathy / Kearns-Sayre)
Last HY Integrations for Myopathies: If severe myopathy + NORMAL CK = consider mitochondrial disorder (HETEROPLASMY is a TQ for Step 1 for the maternal inheritance of mitochondrial diseases) If proximal muscle PAIN + normal CK = consider Polymyalgia Rheumatica
What are 3 diseases associated with this finding? (exacerbated with coughing)
Congenital umbilical hernia! 1) Downs Syndrome 2) Congenital hypothyroidism 3) Beckwith-Wiedemann Syndrome
These mucosal findings + history of Tuberculosis. Labs significant for elevated Chloride and non-anion gap metabolic acidosis:
- Chronic Primary Adrenal Insufficiency! TB is the MCC of adrenal insufficiency in developing world. Don't get trapped into only being able to diagnosis Addison's / adrenal insufficiency by looking for the hyperkalemia & hyponatremia! **POMC breakdown product = MSH
Recall: Secondary adrenal insufficiency does NOT have hyperpigmentation of skin/mucosa OR hyperkalemia (due to intact RAAS system!) Causes of 2ndary adrenal insufficiency = Decreased pituitary ACTH production Mnemonic: "Secondary Spares Skin" whereas "Primary Pigments"
HY Integration: Adrenal Insufficiency + VLCFA (Very Long Chain Fatty Acids) = Adrenoleukodystrophy - Peroxisome Beta oxidation defect causes adrenal glands to build up with VLCFA
Other peroxisome disorders like Adrenoleukodystrophy: - Refsum disease = phytanic acid buildup + scaly skin, ataxia, cataracts, short 4th toe, epiphyseal dysplasia. Tx: plasmapheresis - Zellweger syndrome = PEX mutation + hypotonia, seizures, craniofacial defect, early death
30yo F with HTN. Would this patient have edema or elevated renin/aldosterone?
Yes! Fibromuscular dysplasia Tx: Balloon angioplasty Quick Hyperaldosteronism side note: - Primary = Conn syndrome (adrenal adenoma - see CT) or bilateral adrenal hyperplasia --> NO EDEMA/Renin - Secondary = Renovascular hypertension or JG cell tumor --> EDEMA & ELEVATED RENIN
65yo, fatigued European woman who's family said she's mentally slowing down, with broad-based gait and these findings:
- Glossitis due to Pernicious anemia! Lack of intrinsic factor from parietal cells --> No B12 absorption --> fatigue from anemia + broad based gait from dorsal column degeneration HY Note: Don't forget that Diphyllobothrium latum (fish tapeworm) can cause Vit B12 deficiency
HY Tie-in: Orotic Aciduria, Copper deficiency, Diamond-Blackfan anemia and Fanconi anemia can ALSO have MCV > 100 (Macrocytic anemia) Note: Consider orotic aciduria if anemia does not improve with administration of vitamin B12 or folic acid.
Recall from Step 1: Orotic aciduria = NO HYPERAMMONEMIA - Tx: oral uridine administration vs: Ornithine transcarbamylase (OTC) = HYPERAMMONEMIA - Tx: decreased protein intake and dialysis if ammonia levels > 1000 and refractory to diet Both have orotic acid in urine!
I hope these posts are changing the game for your studying for the NBME / USMLE! If you enjoy these: Do me a favor and share this! (don't just be 1 of the 100's of people that bookmark these reviews & move on!)
Part 1 Review Guide below 👇
If you're a med student and would like to book a free call to discuss study strategy/classes/USMLE/COMLEX/rotations: https://www.actionpotentialmen...
@RushnaChoudhry Hahaha thanks!!